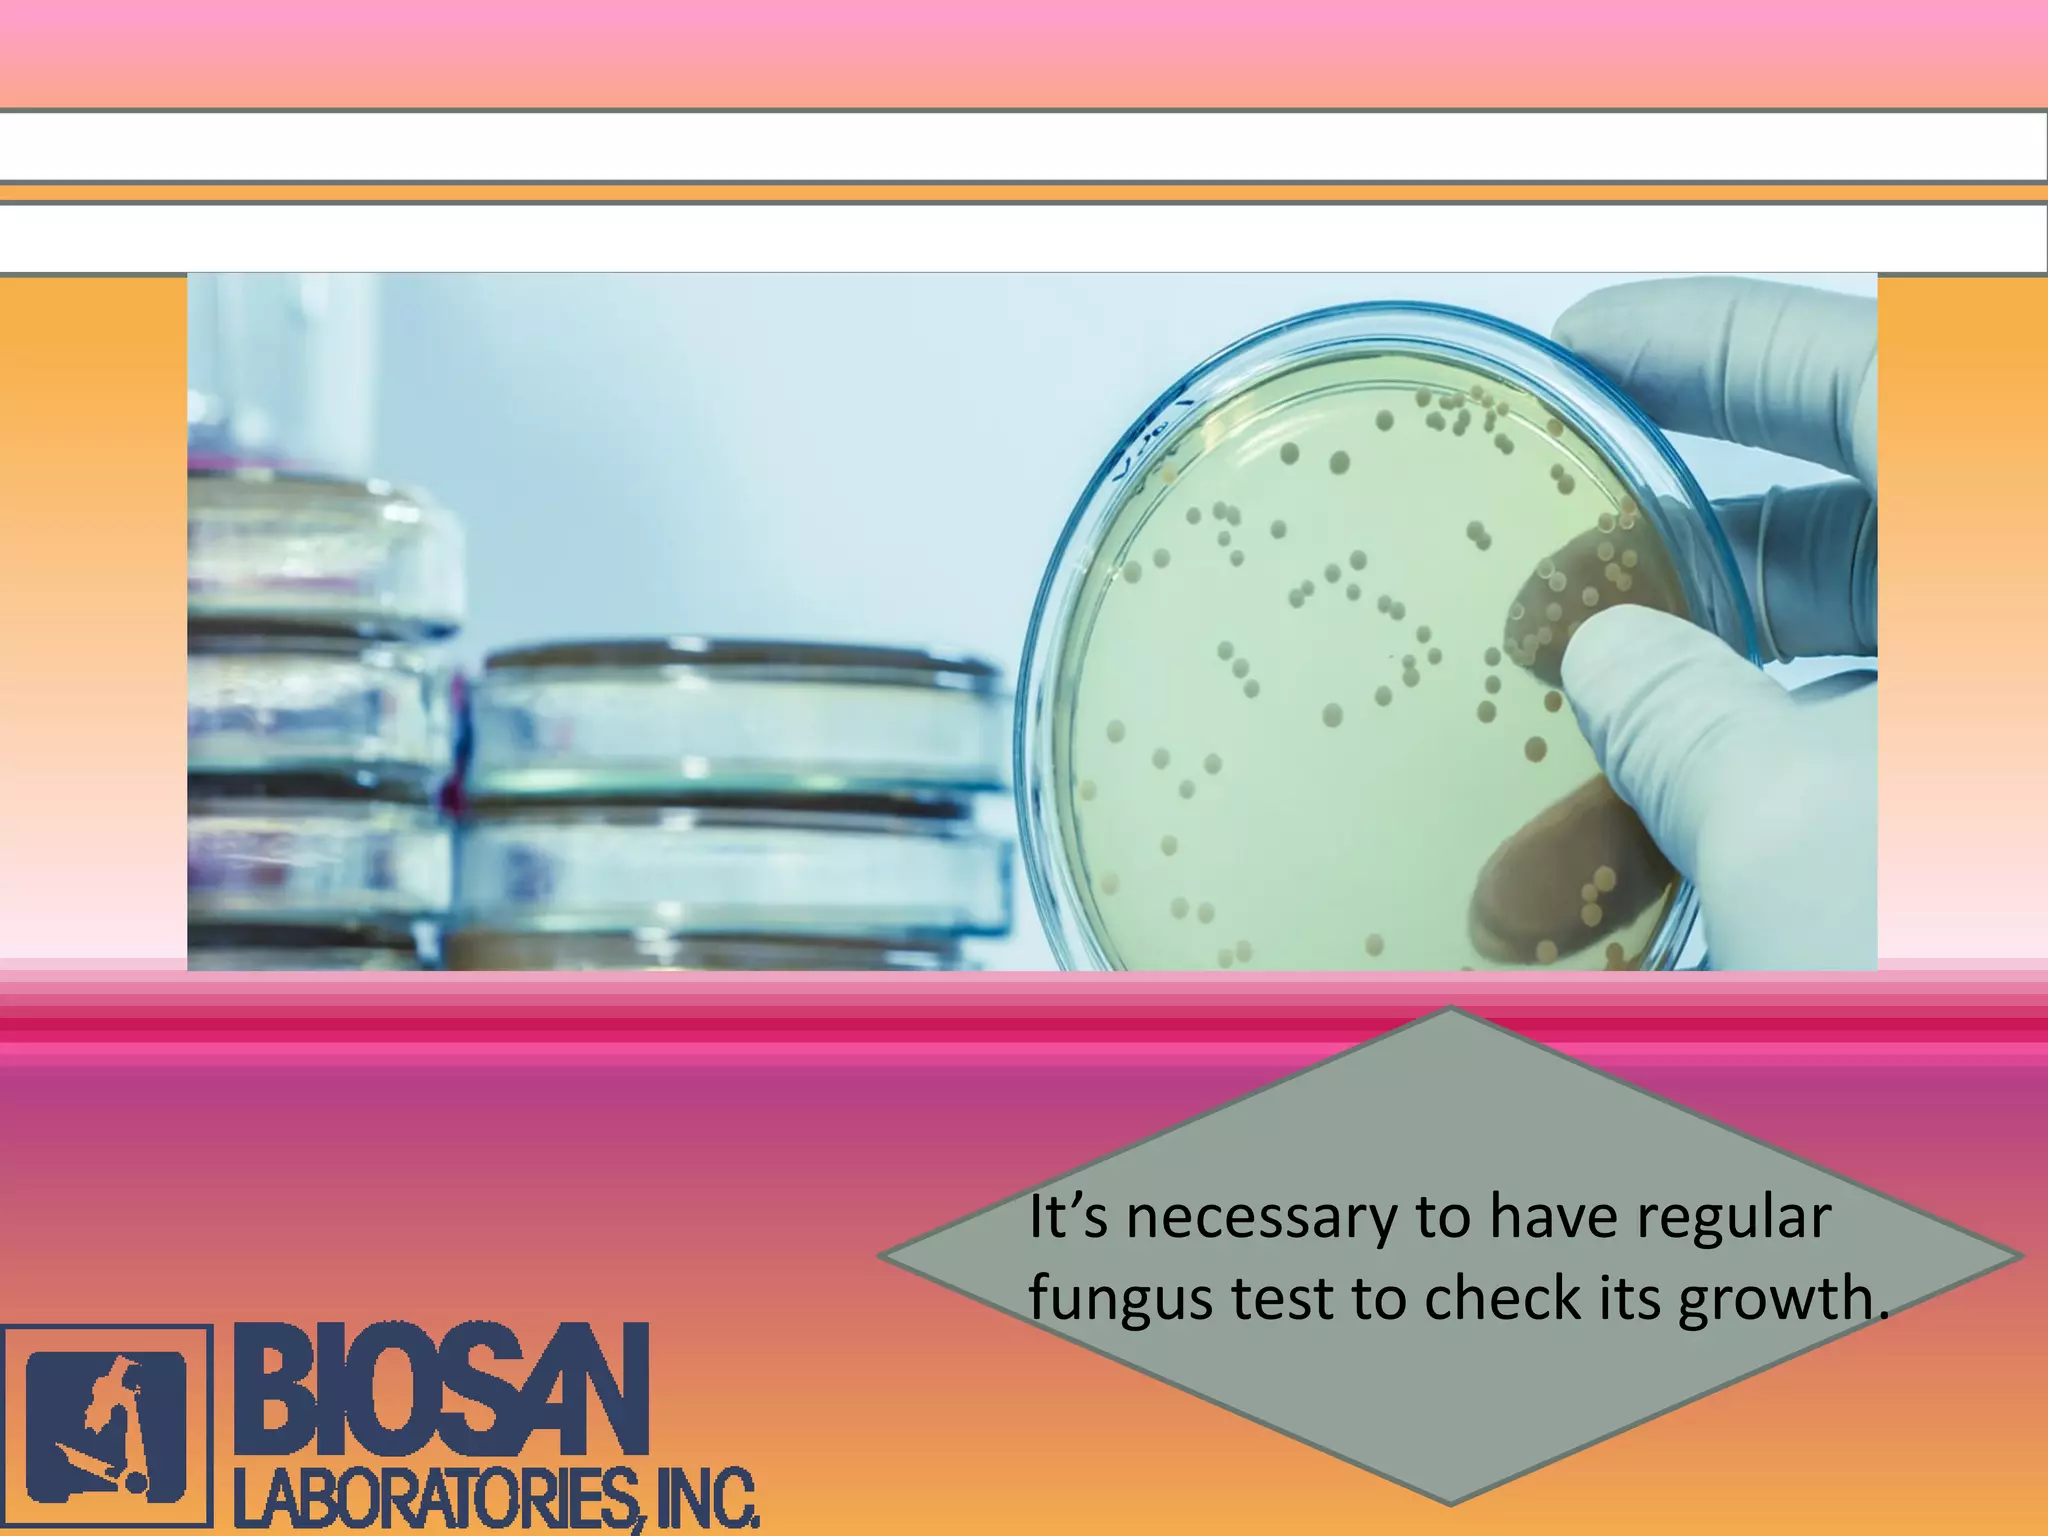
It’s necessary to have regular
fungus test to check its growth.

Embed presentation
Download to read offline
















Fungus is a widespread microorganism that poses risks to industrial premises, potentially leading to costly damage and reduced productivity. Regular fungus testing is essential to identify its presence, and using expert-developed test kits can help in monitoring and managing this risk. Timely action is crucial to protect valuable equipment and maintain a company's reputation.